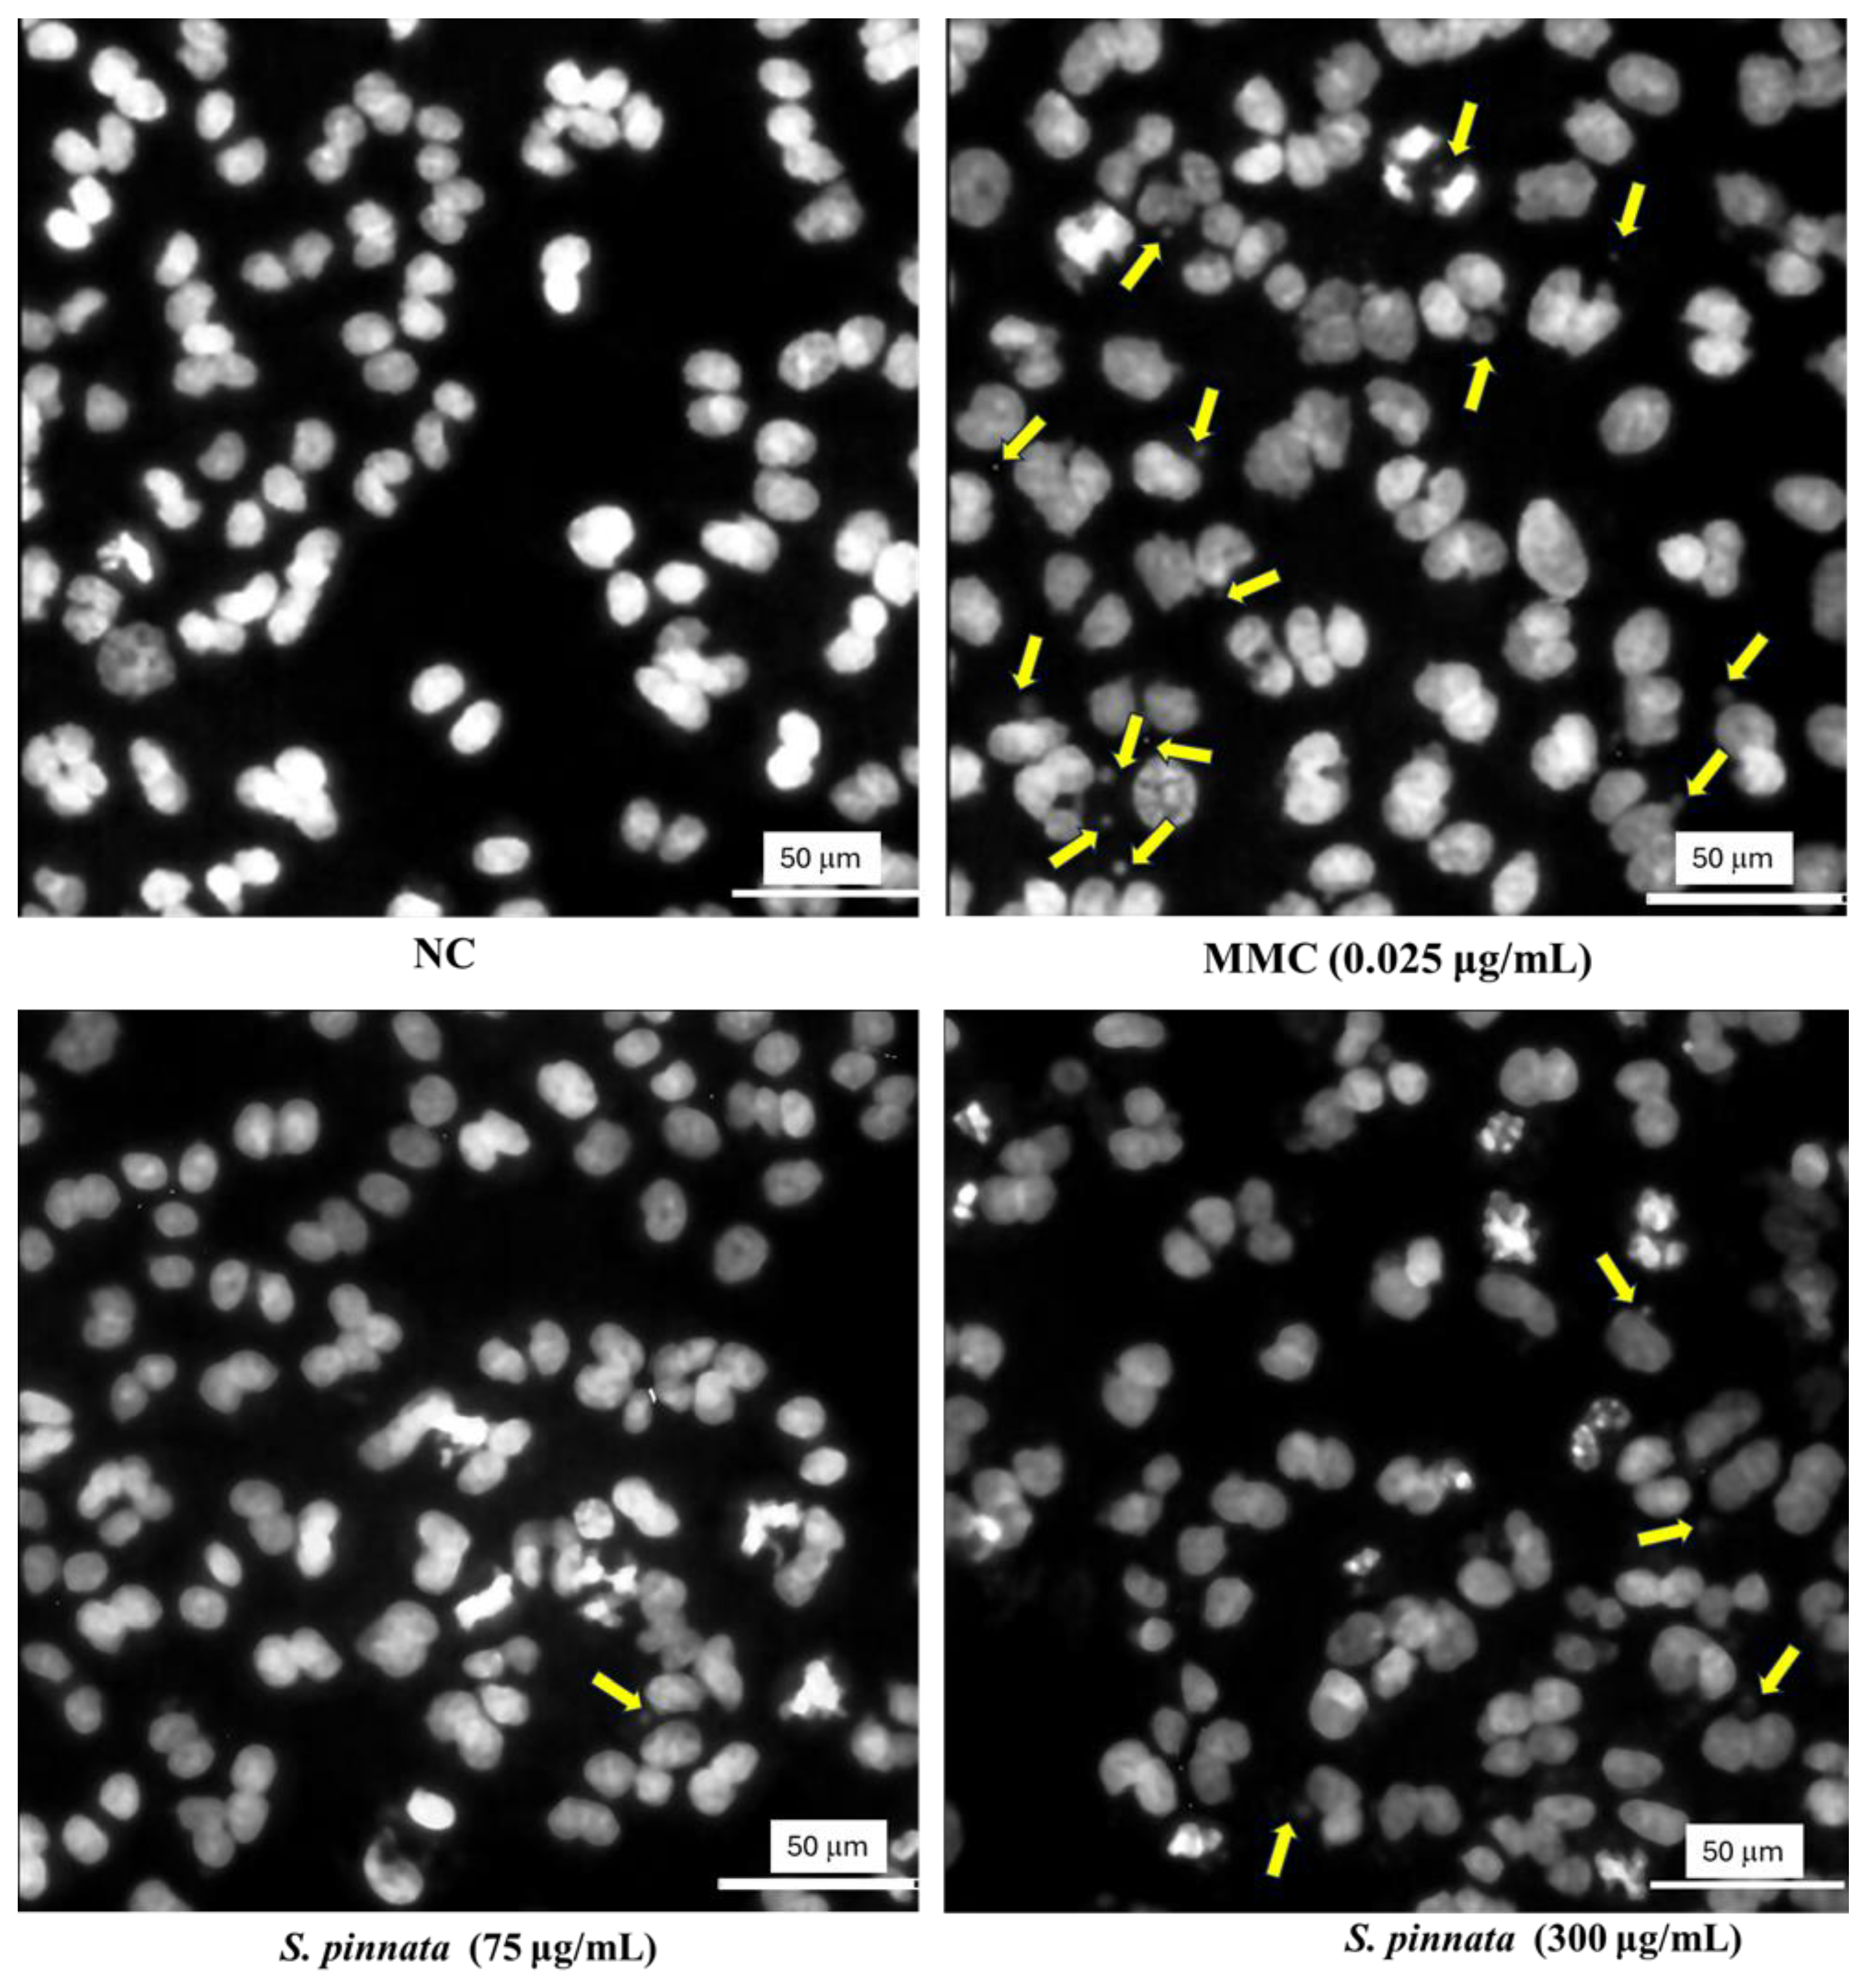
Biomolecules 15 00385 g007

Metabolomic Profiling and In Vitro Evaluation of Cytotoxic, Genotoxic, and Antigenotoxic Effects of Staphylea pinnata L. Extract from Italian Flora
Abstract
1. Introduction
2. Materials and Methods
2.1. Chemicals
2.2. Sample Collections and Extraction
2.3. Preparation of S. pinnata Leaves Methanolic Extract
2.4. Metabolomic Profile of S. pinnata Methanolic Extract
2.5. Cytotoxicity Determination and Dose Selection
2.6. Genotoxicity Study Using CBMN Assay
2.6.1. Genotoxic and Antigenotoxic Study
2.6.2. Cytotoxicity Evaluation Under CBMN Assay
2.6.3. Fluorescence Microscopic Image for MN Detection
2.6.4. Scoring of Binucleated Cells and Micronuclei
2.7. Statistical Analysis
3. Results
3.1. Metabolomic Profile of Specialized Metabolites of S. pinnata Leaf Extract
3.2. Cytotoxicity Evaluation of S. pinnata Extract
3.3. Genotoxicity Assessment Using CBMN Assay
3.3.1. Cytotoxicity and Binucleated Cells Evaluation
3.3.2. Micronuclei Analysis
3.3.3. Antigenotoxicity Determination
4. Discussion
5. Conclusions
Supplementary Materials
Author Contributions
Funding
Institutional Review Board Statement
Informed Consent Statement
Data Availability Statement
Acknowledgments
Conflicts of Interest
References
- Paolillo, I.; Roscigno, G.; Innangi, M.; Zorrilla, J.G.; Petraglia, G.; Russo, M.T.; Carraturo, F.; Guida, M.; Pollice, A.; Cimmino, A.; et al. Health-Promoting Properties of Natural Flavonol Glycosides Isolated from Staphylea pinnata L. Int. J. Mol. Sci. 2024, 25, 5582. [Google Scholar] [CrossRef]
- Madeja, J.; Harmata, K.; Kołaczek, P.; Karpińska-Kołaczek, M.; Piątek, K.; Naks, P. Bracken (Pteridium aquilinum (L.) Kuhn), mistletoe (Viscum album (L.)) and bladder-nut (Staphylea pinnata (L.))-mysterious plants with unusual applications. Culturaland ethnobotanical studies. In Plants and Culture: Seeds of the Cultural Heritage of Europe; Morel, J.-P., Mercuri, A.M., Eds.; Edipuglia: Santo Spirito, Italy, 2009; pp. 207–215. [Google Scholar]
- Heiss, A.G.; FilipoviĆ, D.; Nedelcheva, A.; Ruß-Popa, G.; Wanninger, K.; Schramayr, G.; Perego, R.; Jacomet, S. A Fistful of Bladdernuts: The Shifting Uses of Staphylea pinnata L. as Documented by Archaeology, History, and Ethnology. Folk Life 2014, 52, 95–136. [Google Scholar] [CrossRef]
- Redžić, S.; Ferrier, J. The Use of Wild Plants for Human Nutrition During a War: Eastern Bosnia (Western Balkans). In Ethnobotany and Biocultural Diversities in the Balkans; Pieroni, A., Quave, C., Eds.; Springer: New York, NY, USA, 2014; pp. 149–182. [Google Scholar]
- Sircelj, H.; Vidrih, R.; Veberič, R.; Mikulič-Petkovšek, M. Evaluation of bioactive constituents in European bladdernut (Staphylea pinnata L.) seed kernels. J. Food Compos. Anal. 2019, 78, 33–41. [Google Scholar] [CrossRef]
- Maia, A. Medicinal Remedies is Plant are Species of Staphylea pinnata L. and Family Staphyleaceae Lindl. in the Georgia (South Caucasus). Agric. Res. Technol. 2020, 24, 556255. [Google Scholar]
- Lacikova, L.; Muselik, J.; Masterova, I.; Grancai, D. Antioxidant activity and total phenols in different extracts of four Staphylea L. Species. Molecules 2007, 12, 98–102. [Google Scholar] [CrossRef] [PubMed]
- Lacikova, L.; Jancova, M.; Muselik, J.; Masterova, I.; Grancai, D.; Fickova, M. Antiproliferative, cytotoxic, antioxidant activity and polyphenols contents in leaves of four Staphylea L. species. Molecules 2009, 14, 3259–3267. [Google Scholar] [CrossRef]
- Rutkowska, J.; Pasqualone, A. Plant Extracts as Functional Food Ingredients. Foods 2025, 14, 374. [Google Scholar] [CrossRef]
- Al-Naqeb, G.; Kalmpourtzidou, A.; Giampieri, F.; De Giuseppe, R.; Cena, H. Genotoxic and antigenotoxic medicinal plant extracts and their main phytochemicals: “A review”. Front. Pharmacol. 2024, 15, 1448731. [Google Scholar] [CrossRef]
- De Quadros, A.P.O.; Oshiiwa, B.; Petreanu, M.; Niero, R.; Rosa, P.C.P.; Sawaya, A.C.H.F.; Mantovani, M.S.; O’Neill De Mascarenhas Gaivão, I.; Maistro, E.L. Rubus rosifolius (Rosaceae) stem extract induces cell injury and apoptosis in human hepatoma cell line. Toxicol In Vitro 2023, 86, e105485. [Google Scholar] [CrossRef]
- Quadros Gomes, A.R.; da Rocha Galucio, N.C.; de Albuquerque, K.C.O.; Brígido, H.P.C.; Varela, E.L.P.; Castro, A.L.G.; Vale, V.V.; Bahia, M.O.; Rodriguez Burbano, R.M.; de Molfeta, F.A.; et al. Toxicity evaluation of Eleutherine plicata Herb. extracts and possible cell death mechanism. Toxicol. Rep. 2021, 8, 1480–1487. [Google Scholar] [CrossRef]
- Jantová, S.; Nagy, M.; Ruzeková, L.; Grancai, D. Antibacterial activity of plant extracts from the families Fabaceae, Oleaceae, Philadelphaceae, Rosaceae and Staphyleaceae. Phytother. Res. 2000, 14, 601–603. [Google Scholar] [CrossRef] [PubMed]
- Kim, M.; Jee, S.C.; Shin, M.K.; Han, D.H.; Bu, K.B.; Lee, S.C.; Jang, B.Y.; Sung, J.S. Quercetin and Isorhamnetin Reduce Benzo[a]pyrene-Induced Genotoxicity by Inducing RAD51 Expression through Downregulation of miR-34a. Int. J. Mol. Sci. 2022, 23, 13125. [Google Scholar] [CrossRef]
- Musonda, C.A.; Chipman, J.K. Quercetin inhibits hydrogen peroxide (H2O2)-induced NF-kappaB DNA binding activity and DNA damage in HepG2 cells. Carcinogenesis 1998, 19, 1583–1589. [Google Scholar] [CrossRef] [PubMed]
- Undeğer, U.; Aydin, S.; Başaran, A.A.; Başaran, N. The modulating effects of quercetin and rutin on the mitomycin C induced DNA damage. Toxicol. Lett. 2004, 151, 143–149. [Google Scholar] [CrossRef]
- Engen, A.; Maeda, J.; Wozniak, D.E.; Brents, C.A.; Bell, J.J.; Uesaka, M.; Aizawa, Y.; Kato, T.A. Induction of cytotoxic and genotoxic responses by natural and novel quercetin glycosides. Mutat. Res. Genet. Toxicol. Environ. Mutagen. 2015, 784–785, 15–22. [Google Scholar] [CrossRef]
- Zorzi, G.; Gambini, S.; Negri, S.; Guzzo, F.; Commisso, M. Untargeted Metabolomics Analysis of the Orchid Species Oncidium sotoanum Reveals the Presence of Rare Bioactive C-Diglycosylated Chrysin Derivatives. Plants 2023, 12, 655. [Google Scholar] [CrossRef]
- Santos, G.S.; Tsutsumi, S.; Vieira, D.P.; Bartolini, P.; Okazaki, K. Effect of Brazilian propolis (AF-08) on genotoxicity, cytotoxicity and clonogenic death of Chinese hamster ovary (CHO-K1) cells irradiated with 60Co gamma-radiation. Mutat. Res. Genet. Toxicol. Environ. Mutagen. 2014, 762, 17–23. [Google Scholar] [CrossRef]
- El Hosry, L.; Di Giorgio, C.; Birer, C.; Habib, J.; Tueni, M.; Bun, S.S.; Herbette, G.; De Meo, M.; Ollivier, E.; Elias, R. In vitro cytotoxic and anticlastogenic activities of saxifragifolin B and cyclamin isolated from Cyclamen persicum and Cyclamen libanoticum. Pharm. Biol. 2014, 52, 1134–1140. [Google Scholar] [CrossRef] [PubMed]
- Kirkland, D.; Aardema, M.; Henderson, L.; Müller, L. Evaluation of the ability of a battery of three in vitro genotoxicity tests to discriminate rodent carcinogens and non-carcinogens I. Sensitivity, specificity and relative predictivity. Mutat. Res. 2005, 584, 1–256. [Google Scholar] [CrossRef]
- Al-Naqeb, G.; Zorzi, G.; Oldani, A.; Azzalin, A.; Avesani, L.; Guzzo, F.; Pascale, A.; De Giuseppe, R.; Cena, H. Phytochemical Profile and In Vitro Cytotoxic, Genotoxic, and Antigenotoxic Evaluation of Cistus monspeliensis L. Leaf Extract. Int. J. Mol. Sci. 2024, 25, 13707. [Google Scholar] [CrossRef]
- Organization for Economic Co-operation and Development (OECD). Test No. 487: In Vitro Mammalian Cell Micronucleus Test. In OECD Guidelines for the Testing of Chemicals; Section 4; OECD Publishing: Paris, France, 2023. [Google Scholar]
- Phelps, J.B.; Garriott, M.L.; Hoffman, W.P. A protocol for the in vitro micronucleus test. II. Contributions to the validation of a protocol suitable for regulatory submissions from an examination of 10 chemicals with different mechanisms of action and different levels of activity. Mutat. Res. 2002, 521, 103–112. [Google Scholar] [CrossRef]
- Ramadhani, D.; Purnami, S. Automated Detection of Binucleated Cell and Micronuclei using CellProfiler 2.0 Software. Hayati J. Biosci. 2013, 20, 151–156. [Google Scholar] [CrossRef]
- Salunke, M.; Wakure, B.; Wakte, P. HR-LCMS assisted phytochemical screening and an assessment of anticancer activity of Sargassum Squarrossum and Dictyota Dichotoma using in vitro and molecular docking approaches. J. Mol. Struct. 2022, 1270, 133833. [Google Scholar] [CrossRef]
- Hashimoto, K.; Nakajima, Y.; Matsumura, S.; Chatani, F. Comparison of four different treatment conditions of extended ex-posure in the in vitro micronucleus assay using TK6 lymphoblastoid cells. Regul. Toxicol. Pharmacol. 2011, 59, 28–36. [Google Scholar] [CrossRef]
- Rajasekar, N.; Sivanantham, A.; Ravikumar, V.; Rajasekaran, S. An overview on the role of plant-derived tannins for the treatment of lung cancer. Phytochemistry 2021, 188, 112799. [Google Scholar] [CrossRef] [PubMed]
- Li, W.; He, Y.; Zhao, H.; Peng, L.; Li, J.; Rui, R.; Ju, S. Grape Seed Proanthocyanidin Ameliorates FB1-Induced Meiotic Defects in Porcine Oocytes. Toxins 2021, 13, 841. [Google Scholar] [CrossRef] [PubMed]
- Enomoto, T.; Nagasako-Akazome, Y.; Kanda, T.; Ikeda, M.; Dake, Y. Clinical effects of apple polyphenols on persistent allergic rhinitis: A randomized double-blind placebo-controlled parallel arm study. Investig. Allergol. Clin. Immunol. 2006, 16, 283–289. [Google Scholar]
- Grace, M.H.; Xiong, J.; Esposito, D.; Ehlenfeldt, M.; Lila, M.A. Simultaneous LC-MS quantification of anthocyanins and non-anthocyanin phenolics from blueberries with widely divergent profiles and biological activities. Food. Chem. 2019, 277, 336–346. [Google Scholar] [CrossRef]
- Nawrot-Hadzik, I.; Matkowski, A.; Hadzik, J.; Dobrowolska-Czopor, B.; Olchowy, C.; Dominiak, M.; Kubasiewicz-Ross, P. Proanthocyanidins and Flavan-3-Ols in the Prevention and Treatment of Periodontitis-Antibacterial Effects. Nutrients 2021, 13, 165. [Google Scholar] [CrossRef]
- Tian, Y.; Yang, C.; Yao, Q.; Qian, L.; Liu, J.; Xie, X.; Ma, W.; Nie, X.; Lai, B.; Xiao, L.; et al. Procyanidin B2 Activates PPARγ to Induce M2 Polarization in Mouse Macrophages. Front. Immunol. 2019, 10, 1895. [Google Scholar] [CrossRef]
- Choy, Y.Y.; Fraga, M.; Mackenzie, G.G.; Waterhouse, A.L.; Cremonini, E.; Oteiza, P.I. The PI3K/Akt pathway is involved in procyanidin-mediated suppression of human colorectal cancer cell growth. Mol. Carcinog. 2016, 55, 2196–2209. [Google Scholar] [CrossRef] [PubMed]
- Sazwi, N.N.; Nalina, T.; Abdul Rahim, Z.H. Antioxidant and cytoprotective activities of Piper betle, Areca catechu, Uncaria gambir and betel quid with and without calcium hydroxide. BMC Complement. Altern. Med. 2013, 13, 351. [Google Scholar]
- Wang, Q.Q.; Gao, H.; Yuan, R.; Han, S.; Li, X.X.; Tang, M.; Dong, B.; Li, J.X.; Zhao, L.C.; Feng, J.; et al. Procyanidin A2, a polyphenolic compound, exerts anti-inflammatory and anti-oxidative activity in lipopolysaccharide-stimulated RAW264.7 cells. PLoS ONE 2020, 15, e0237017. [Google Scholar] [CrossRef]
- Lee, Y.A.; Cho, E.J.; Tanaka, T.; Yokozawa, T. Inhibitory activities of proanthocyanidins from persimmon against oxidative stress and digestive enzymes related to diabetes. J. Nutr. Sci. Vitaminol. 2007, 53, 287–292. [Google Scholar] [CrossRef]
- Tang, J.; Li, B.; Hong, S.; Liu, C.; Min, J.; Hu, M.; Li, Y.; Liu, Y.; Hong, L. Punicalagin suppresses the proliferation and invasion of cervical cancer cells through inhibition of the β-catenin pathway. Mol. Med. Rep. 2017, 16, 1439–1444. [Google Scholar] [CrossRef]
- Carneiro, C.C.; da Costa Santos, S.; de Souza Lino, R.; Bara, M.T., Jr.; Chaibub, B.A.; de Melo Reis, P.R.; Chaves, D.A.; da Silva, A.J.; Silva, L.S.; de Melo e Silva, D.; et al. Chemopreventive effect and angiogenic activity of punicalagin isolated from leaves of Lafoensia pacari A. St.-Hil. Toxicol. Appl. Pharmacol. 2016, 310, 1–8. [Google Scholar] [CrossRef] [PubMed]
- Moretti, M.; Cossignani, L.; Messina, F.; Dominici, L.; Villarini, M.; Curini, M.; Marcotullio, M.C. Antigenotoxic effect, composition and antioxidant activity of Dendrobium speciosum. Food Chem. 2013, 140, 660–665. [Google Scholar] [CrossRef]
- Rondini, T.; Branciari, R.; Franceschini, E.; Acito, M.; Fatigoni, C.; Roila, R.; Ranucci, D.; Villarini, M.; Galarini, R.; Moretti, M. Olive Mill Wastewater Extract: In Vitro Genotoxicity/Antigenotoxicity Assessment on HepaRG Cells. Int. J. Environ. Res. Public Health 2024, 21, 1050. [Google Scholar] [CrossRef]
- Cvetković, S.; Todorović, S.; Nastasijević, B.; Mitić-Ćulafić, D.; Đukanović, S.; Knežević-Vukčević, J.; Nikolić, B. Assessment of genoprotective effects of Gentiana lutea extracts prepared from plants grown in field and in vitro. Ind. Crops Prod. 2020, 154, 112690. [Google Scholar] [CrossRef]
- Ananthi, R.; Chandra, N.; Santhiya, S.T.; Ramesh, A. Genotoxic and antigenotoxic effects of Hemidesmus indicus R. Br. root extract in cultured lymphocytes. J. Ethnopharmacol. 2010, 127, 558–560. [Google Scholar] [CrossRef] [PubMed]
- Kuhn, A.W.; Tedesco, M.; Laughinghouse, H.D.; Flores, F.C.; Silva, C.D.; Canto-Dorow, T.S.; Tedesco, S.B. Mutagenic and antimutagenic effects of Eugenia uniflora L. by the Allium cepa L. test. Caryologia 2015, 68, 25–30. [Google Scholar] [CrossRef]
- Nicolella, H.D.; de Oliveira, P.F.; Munari, C.C.; Costa, G.F.; Moreira, M.R.; Veneziani, R.C.; Tavares, D.C. Differential effect of manool a diterpene from Salvia officinalis, on genotoxicity induced by methyl methanesulfonate in V79 and HepG2 cells. Food Chem. Toxicol. 2014, 72, 8–12. [Google Scholar] [CrossRef] [PubMed]
- Jakovljević, M.R.; Grujičić, D.; Vukajlović, J.T.; Markovic, A.; Milutinović, M.G.; Stanković, M.S.; Vukovic, N.L.; Vukić, M.D.; Milošević-Djordjević, O. In vitro study of genotoxic and cytotoxic activities of methanol extracts of Artemisia vulgaris L. and Artemisia alba Turra. S. Afr. J. Bot. 2020, 132, 117–126. [Google Scholar] [CrossRef]
- Vaou, N.; Stavropoulou, E.; Voidarou, C.C.; Tsakris, Z.; Rozos, G.; Tsigalou, C.; Bezirtzoglou, E. Interactions between Medical Plant-Derived Bioactive Compounds: Focus on Antimicrobial Combination Effects. Antibiotics 2022, 11, 1014. [Google Scholar] [CrossRef]
- Azqueta, A.; Collins, A. Polyphenols and DNA Damage: A Mixed Blessing. Nutrients 2016, 8, 785. [Google Scholar] [CrossRef]
- Utesch, D.; Feige, K.; Dasenbrock, J.; Broschard, T.H.; Harwood, M.; Danielewska-Nikiel, B.; Lines, T.C. Evaluation of the potential in vivo genotoxicity of quercetin. Mutat. Res. 2008, 654, 38–44. [Google Scholar] [CrossRef]
- Hobbs, C.A.; Koyanagi, M.; Swartz, C.; Davis, J.; Kasamoto, S.; Maronpot, R.; Recio, L.; Hayashi, S.M. Comprehensive evaluation of the flavonol anti-oxidants, alpha-glycosyl isoquercitrin and isoquercitrin, for genotoxic potential. Food Chem. Toxicol. 2018, 113, 218–227. [Google Scholar] [CrossRef]
- Yamakoshi, J.; Saito, M.; Kataoka, S.; Kikuchi, M. Safety evaluation of proanthocyanidin-rich extract from grape seeds. Food Chem. Toxicol. 2002, 40, 599–607. [Google Scholar] [CrossRef]
- Erexson, G.L. Lack of in vivo clastogenic activity of grape seed and grape skin extracts in a mouse micronucleus assay. Food Chem. Toxicol. 2003, 41, 347–350. [Google Scholar] [CrossRef] [PubMed]
- Llópiz, N.; Puiggròs, F.; Céspedes, E.; Arola, L.; Ardévol, A.; Bladé, C.; Salvadó, M.J. Antigenotoxic effect of grape seed procyanidin extract in Fao cells submitted to oxidative stress. J. Agric. Food Chem. 2004, 52, 1083–1087. [Google Scholar] [CrossRef] [PubMed]
- Costa, M.A.; Ishida, K.; Kaplum, V.; Koslyk, E.D.; de Mello, J.C.; Ueda-Nakamura, T.; Dias Filho, B.P.; Nakamura, C.V. Safety evaluation of proanthocyanidin polymer-rich fraction obtained from stem bark of Stryphnodendron adstringens (BARBATIMAO) for use as a pharmacological agent. Regul. Toxicol. Pharmacol. 2010, 58, 330–335. [Google Scholar] [CrossRef]
- Roig, R.; Cascón, E.; Arola, L.; Bladé, C.; Salvadó, M.J. Moderate wine consumption protects the rat against oxidation in vivo. Life Sci. 1999, 64, 1517–1524. [Google Scholar] [CrossRef] [PubMed]
- Roig, R.; Cascón, E.; Arola, L.; Bladé, C.; Salvadó, M.J. Procyanidins protect Fao cells against hydrogen peroxide-induced oxidative stress. Biochim. Biophys. Acta. 2002, 1572, 25–30. [Google Scholar] [CrossRef]
- Haslam, E. Natural polyphenols (vegetable tannins) as drugs: Possible modes of action. J. Nat. Prod. 1996, 59, 205–215. [Google Scholar] [CrossRef]

| Peak Number | Compound Name | Pool 1 | Pool 2 | Pool 3 | Mean | STD |
|---|---|---|---|---|---|---|
| 1 | Citric acid | 511.00 | 1116.00 | 574.00 | 733.67 | 297.49 |
| 2 | Dimeric lignin (coniferyl alcohol derivative) | 2428.54 | 1725.64 | 2077.01 | 2077.07 | 314.35 |
| 3 | Prodelphinidin trimer 1 | 6983.25 | 7073.67 | 3991.68 | 6016.20 | 1568.71 |
| 4 | Procyanidin trimer 1 | 32,232.76 | 28,374.76 | 16,314.96 | 25,640.83 | 7426.97 |
| 5 | Piscidic acid | 1922.00 | 3984.00 | 1991.00 | 2632.33 | 1047.45 |
| 6 | Prodelphinidin dimer 1 | 9874.15 | 10,441.22 | 5545.04 | 8620.14 | 2395.42 |
| 7 | Dihydroxybenzoic acid derivative | 5822.43 | 4847.15 | 5390.92 | 5353.50 | 437.12 |
| 8 | Procyanidin dimer 1 | 105,135.88 | 91,645.37 | 56,324.36 | 84,368.54 | 22,545.16 |
| 9 | Procyanidin dimer 2 | 50,754.83 | 46,068.60 | 25,793.22 | 40,872.21 | 11,866.67 |
| 10 | Procyanidin trimer 2 | 3683.00 | 3535.00 | 1618.00 | 2945.33 | 1030.28 |
| 11 | Catechin | 38,654.00 | 35,950.00 | 22,206.00 | 32,270.00 | 7888.78 |
| 12 | Procyanidin trimer 3 | 91,430.89 | 86,030.83 | 50,579.56 | 76,013.76 | 19,848.71 |
| 13 | Procyanidin tetramer 1 | 34,292.34 | 33,138.63 | 19,219.69 | 28,883.55 | 7503.36 |
| 14 | Procyanidin pentamer 1 | 26,054.97 | 25,956.82 | 14,713.18 | 22,241.66 | 5831.70 |
| 15 | Benzyl alcohol-O-hexoside-pentoside | 6665.07 | 6029.68 | 6905.57 | 6533.44 | 404.76 |
| 16 | Procyanidin trimer 4 | 22,770.24 | 21,524.11 | 12,379.30 | 18,891.22 | 5074.80 |
| 17 | Caffeoyl malic acid | 153.00 | 121.00 | 68.00 | 114.00 | 38.40 |
| 18 | Procyanidin dimer 3 | 10,106.00 | 8839.00 | 4776.00 | 7907.00 | 2490.57 |
| 19 | Quercetin-O-rutinoside | 38,144.35 | 30,459.67 | 29,199.06 | 32,601.03 | 4330.69 |
| 20 | Quercetin-O-hexoside | 15,264.34 | 13,449.42 | 11,052.62 | 13,255.46 | 1889.52 |
| 21 | Quercetin-O-malonylhexoside | 11,796.04 | 9409.35 | 9075.77 | 10,093.72 | 1327.02 |
| 22 | Isorhamnetin-O-rutinoside | 18,728.16 | 16,116.04 | 15,764.19 | 16,869.47 | 1448.31 |
| 23 | Isorhamnetin-O-hexoside | 13,694.87 | 12,686.62 | 9526.32 | 11,969.27 | 1945.28 |
| 24 | Isorhamnetin-O-malonylhexoside | 22,373.07 | 18,442.05 | 16,459.41 | 19,091.51 | 2692.09 |
| 25 | Asiatic acid | 5178.89 | 4480.20 | 4386.19 | 4681.76 | 387.36 |
| 26 | Asiatic acid isomer | 4763.01 | 4240.51 | 4323.26 | 4442.26 | 251.19 |
| 27 | Maslinic acid | 21,692.20 | 20,709.16 | 20,638.08 | 21,013.14 | 526.95 |
| 28 | Maslinic acid isomer | 12,830.20 | 12,069.47 | 12,129.90 | 12,343.19 | 378.21 |
| 29 | Oleanolic acid | 2769.13 | 2637.53 | 2565.13 | 2657.26 | 92.50 |
Disclaimer/Publisher’s Note: The statements, opinions and data contained in all publications are solely those of the individual author(s) and contributor(s) and not of MDPI and/or the editor(s). MDPI and/or the editor(s) disclaim responsibility for any injury to people or property resulting from any ideas, methods, instructions or products referred to in the content. |
© 2025 by the authors. Licensee MDPI, Basel, Switzerland. This article is an open access article distributed under the terms and conditions of the Creative Commons Attribution (CC BY) license (https://creativecommons.org/licenses/by/4.0/).
Share and Cite
Al-Naqeb, G.; Pietrolucci, F.; Commisso, M.; Kalmpourtzidou, A.; Oldani, A.; Boussetta, S.; Maccarini, B.; De Giuseppe, R.; Cena, H. Metabolomic Profiling and In Vitro Evaluation of Cytotoxic, Genotoxic, and Antigenotoxic Effects of Staphylea pinnata L. Extract from Italian Flora. Biomolecules 2025, 15, 385. https://doi.org/10.3390/biom15030385
Al-Naqeb G, Pietrolucci F, Commisso M, Kalmpourtzidou A, Oldani A, Boussetta S, Maccarini B, De Giuseppe R, Cena H. Metabolomic Profiling and In Vitro Evaluation of Cytotoxic, Genotoxic, and Antigenotoxic Effects of Staphylea pinnata L. Extract from Italian Flora. Biomolecules. 2025; 15(3):385. https://doi.org/10.3390/biom15030385
Chicago/Turabian StyleAl-Naqeb, Ghanya, Fabio Pietrolucci, Mauro Commisso, Aliki Kalmpourtzidou, Amanda Oldani, Sara Boussetta, Beatrice Maccarini, Rachele De Giuseppe, and Hellas Cena. 2025. "Metabolomic Profiling and In Vitro Evaluation of Cytotoxic, Genotoxic, and Antigenotoxic Effects of Staphylea pinnata L. Extract from Italian Flora" Biomolecules 15, no. 3: 385. https://doi.org/10.3390/biom15030385
APA StyleAl-Naqeb, G., Pietrolucci, F., Commisso, M., Kalmpourtzidou, A., Oldani, A., Boussetta, S., Maccarini, B., De Giuseppe, R., & Cena, H. (2025). Metabolomic Profiling and In Vitro Evaluation of Cytotoxic, Genotoxic, and Antigenotoxic Effects of Staphylea pinnata L. Extract from Italian Flora. Biomolecules, 15(3), 385. https://doi.org/10.3390/biom15030385

